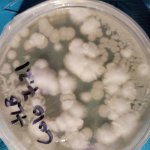
20220726_054514.jpg

This idea was inspired by dreamer042 who encouraged me to share about my mushroom cultivation journey. So thank you, dreamer.
I started this maybe a year and half ago, but really took off with some confidence in the past six months, so will start by sharing everything up until now in a concise manner. If there are any questions feel free to ask and I'll provide further specificity.
The first pics show the results of the BRF cake tek. The very first ones are from over a year ago. Some of the later ones are much more recent. I actually will no longer be using the BRF method any longer. I find it too be too much work for too little yield when compared to the monotub. I went so long doing both because I'm neurotic, and if I open a spore syringe then I want to use all of it. And bulk grain (such as rye berries which are my present grain choice for inoculation) doesn't seem to colonize well with spores. Using a whole spore syringe for a couple liquid cultures is not ideal, so would always inoculate a few BRF jars as well. However, now, I have decided there's little concern for only using part of a syringe. The last cakes that I will be working with are presently in their respective terrariums.
The main mushrooms shown on cakes are Penis Envy and Amazonian.
The first monotub photos show Hillbilly, a strain out of Arkansas.
The next ones will be White Teachers. You'll be able to tell the difference.
And there are some other relevant pics just for fun.
As of now, I have four monotubs going and finishing up cakes with 11 of them (six of which are on their second flush) I plan to inoculate about 7 bags this evening. I have several more bags awaiting results of colonization.
Thank you for viewing. I hope you enjoy.
One love
I started this maybe a year and half ago, but really took off with some confidence in the past six months, so will start by sharing everything up until now in a concise manner. If there are any questions feel free to ask and I'll provide further specificity.
The first pics show the results of the BRF cake tek. The very first ones are from over a year ago. Some of the later ones are much more recent. I actually will no longer be using the BRF method any longer. I find it too be too much work for too little yield when compared to the monotub. I went so long doing both because I'm neurotic, and if I open a spore syringe then I want to use all of it. And bulk grain (such as rye berries which are my present grain choice for inoculation) doesn't seem to colonize well with spores. Using a whole spore syringe for a couple liquid cultures is not ideal, so would always inoculate a few BRF jars as well. However, now, I have decided there's little concern for only using part of a syringe. The last cakes that I will be working with are presently in their respective terrariums.
The main mushrooms shown on cakes are Penis Envy and Amazonian.
The first monotub photos show Hillbilly, a strain out of Arkansas.
The next ones will be White Teachers. You'll be able to tell the difference.
And there are some other relevant pics just for fun.
As of now, I have four monotubs going and finishing up cakes with 11 of them (six of which are on their second flush) I plan to inoculate about 7 bags this evening. I have several more bags awaiting results of colonization.
Thank you for viewing. I hope you enjoy.
One love
Attachments
-
 20201010_163231.jpg3.7 MB · Views: 6
20201010_163231.jpg3.7 MB · Views: 6 -
 20220710_121103.jpg2.3 MB · Views: 6
20220710_121103.jpg2.3 MB · Views: 6 -
 20220710_121119.jpg2.2 MB · Views: 5
20220710_121119.jpg2.2 MB · Views: 5 -
 20220713_184215.jpg3 MB · Views: 5
20220713_184215.jpg3 MB · Views: 5 -
 20220713_184218.jpg2.5 MB · Views: 4
20220713_184218.jpg2.5 MB · Views: 4 -
 20220713_184238.jpg2.5 MB · Views: 5
20220713_184238.jpg2.5 MB · Views: 5 -
 20220713_185231.jpg2.5 MB · Views: 5
20220713_185231.jpg2.5 MB · Views: 5 -
 20220719_060621.jpg1.5 MB · Views: 5
20220719_060621.jpg1.5 MB · Views: 5 -
 20220719_060623.jpg1.5 MB · Views: 5
20220719_060623.jpg1.5 MB · Views: 5 -
 20220719_180244.jpg2 MB · Views: 5
20220719_180244.jpg2 MB · Views: 5 -
 20220719_180306.jpg1.7 MB · Views: 4
20220719_180306.jpg1.7 MB · Views: 4 -
 20220726_054205.jpg2.3 MB · Views: 6
20220726_054205.jpg2.3 MB · Views: 6 -
20220726_054514.jpg2.4 MB · Views: 7
20220726_054514.jpg2.4 MB · Views: 7 -
 20220801_182543.jpg1.6 MB · Views: 7
20220801_182543.jpg1.6 MB · Views: 7 -
 20220801_182546.jpg1.8 MB · Views: 7
20220801_182546.jpg1.8 MB · Views: 7 -
 20220803_183906.jpg2.3 MB · Views: 9
20220803_183906.jpg2.3 MB · Views: 9 -
 20220805_182037.jpg2.6 MB · Views: 9
20220805_182037.jpg2.6 MB · Views: 9 -
 20220710_121007.jpg1.6 MB · Views: 7
20220710_121007.jpg1.6 MB · Views: 7 -
 20220709_181339.jpg2.6 MB · Views: 5
20220709_181339.jpg2.6 MB · Views: 5 -
 20201020_170222.jpg4.8 MB · Views: 7
20201020_170222.jpg4.8 MB · Views: 7 -
 20211005_172542.jpg2.4 MB · Views: 7
20211005_172542.jpg2.4 MB · Views: 7 -
 20220415_063137.jpg2 MB · Views: 6
20220415_063137.jpg2 MB · Views: 6 -
 20220429_223900.jpg1.8 MB · Views: 5
20220429_223900.jpg1.8 MB · Views: 5 -
 20220522_114926.jpg2.2 MB · Views: 5
20220522_114926.jpg2.2 MB · Views: 5 -
 20220522_114948.jpg1.5 MB · Views: 5
20220522_114948.jpg1.5 MB · Views: 5 -
 20220522_114955.jpg1.5 MB · Views: 4
20220522_114955.jpg1.5 MB · Views: 4 -
 20220529_211216.jpg2.3 MB · Views: 4
20220529_211216.jpg2.3 MB · Views: 4 -
 20220529_211227.jpg1.6 MB · Views: 4
20220529_211227.jpg1.6 MB · Views: 4 -
 20220709_155510.jpg2.1 MB · Views: 5
20220709_155510.jpg2.1 MB · Views: 5 -
 20220618_173248.jpg2.3 MB · Views: 5
20220618_173248.jpg2.3 MB · Views: 5 -
 20220618_173230.jpg2.3 MB · Views: 5
20220618_173230.jpg2.3 MB · Views: 5 -
 20220608_182607.jpg1.7 MB · Views: 7
20220608_182607.jpg1.7 MB · Views: 7 -
 20220531_062807.jpg2.6 MB · Views: 7
20220531_062807.jpg2.6 MB · Views: 7 -
 20220531_062804.jpg2.6 MB · Views: 7
20220531_062804.jpg2.6 MB · Views: 7 -
 20220529_211946.jpg1.6 MB · Views: 5
20220529_211946.jpg1.6 MB · Views: 5


 .
.


